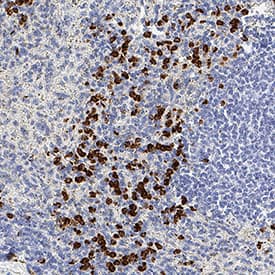

Human CEACAM-8/CD66b Antibody
R&D Systems, part of Bio-Techne | Catalog # MAB4246
Recombinant Monoclonal Antibody.


Conjugate
Catalog #
Key Product Details
Species Reactivity
Validated:
Human
Cited:
Human
Applications
Validated:
Immunohistochemistry, Western Blot, Flow Cytometry, COMET, CyTOF-ready
Cited:
Immunohistochemistry-Paraffin
Label
Unconjugated
Antibody Source
Recombinant Monoclonal Mouse IgG1 Clone # 913542
Product Specifications
Immunogen
E.coli-derived recombinant human CEACAM-8/CD66b
Gln35-His141
Accession # P31997
Gln35-His141
Accession # P31997
Specificity
Detects human CEACAM-8/CD66b in direct ELISAs and Western blots.
Clonality
Monoclonal
Host
Mouse
Isotype
IgG1
Scientific Data Images for Human CEACAM-8/CD66b Antibody
Detection of CEACAM-8 in Human Colon Cancer via seqIF™ staining on COMET™
CEACAM-8 was detected in immersion fixed paraffin-embedded sections of human colon cancer using Mouse Anti-Human CEACAM-8, Monoclonal Antibody (Catalog #MAB4246) at 1ug/mL at 37° Celsius for 4 minutes. Before incubation with the primary antibody, tissue underwent an all-in-one dewaxing and antigen retrieval preprocessing using PreTreatment Module (PT Module)and Dewax and HIER Buffer H (pH 9; Epredia Catalog #TA-999-DHBH). Tissue was stained using the Alexa Fluor™ 647 Goat anti-Mouse IgG Secondary Antibody at 1:200 at 37 ° Celsius for 2 minutes. (Yellow; Lunaphore Catalog # DR647MS) and counterstained with DAPI (blue; Lunaphore Catalog # DR100). Specific staining was localized to the membrane. Protocol available in COMET™ Panel Builder.Detection of CEACAM-8 in Human Hodgkin Lymphoma via seqIF™ staining on COMET™
CEACAM-8 was detected in immersion fixed paraffin-embedded sections of human Hodgkin Lymphoma using Mouse Anti-Human CEACAM-8, Monoclonal Antibody (Catalog #MAB4246) at 1ug/mL at 37° Celsius for 4 minutes. Before incubation with the primary antibody, tissue underwent an all-in-one dewaxing and antigen retrieval preprocessing using PreTreatment Module (PT Module)and Dewax and HIER Buffer H (pH 9; Epredia Catalog #TA-999-DHBH). Tissue was stained using the Alexa Fluor™ 647 Goat anti-Mouse IgG Secondary Antibody at 1:200 at 37 ° Celsius for 2 minutes. (Yellow; Lunaphore Catalog # DR647MS) and counterstained with DAPI (blue; Lunaphore Catalog # DR100). Specific staining was localized to the membrane. Protocol available in COMET™ Panel Builder.Detection of CEACAM-8 in Human Tonsil via seqIF™ staining on COMET™
CEACAM-8 was detected in immersion fixed paraffin-embedded sections of human tonsil using Mouse Anti-Human CEACAM-8, Monoclonal Antibody (Catalog #MAB4246) at 1ug/mL at 37° Celsius for 4 minutes. Before incubation with the primary antibody, tissue underwent an all-in-one dewaxing and antigen retrieval preprocessing using PreTreatment Module (PT Module) and Dewax and HIER Buffer H (pH 9; Epredia Catalog #TA-999-DHBH). Tissue was stained using the Alexa Fluor™ 647 Goat anti-Mouse IgG Secondary Antibody at 1:200 at 37 ° Celsius for 2 minutes. (Yellow; Lunaphore Catalog # DR647MS) and counterstained with DAPI (blue; Lunaphore Catalog # DR100). Specific staining was localized to the membrane. Protocol available in COMET™ Panel Builder.Applications for Human CEACAM-8/CD66b Antibody
Application
Recommended Usage
COMET
1 µg/mL
Sample: Immersion fixed paraffin-embedded sections of human Colon Cancer, Hodgkin Lymphoma and Tonsil
Sample: Immersion fixed paraffin-embedded sections of human Colon Cancer, Hodgkin Lymphoma and Tonsil
CyTOF-ready
Ready to be labeled using established conjugation methods. No BSA or other carrier proteins that could interfere with conjugation.
Flow Cytometry
0.25 µg/106 cells
Sample: Human peripheral blood granulocytes
Sample: Human peripheral blood granulocytes
Immunohistochemistry
0.5-25 µg/mL
Sample: Immersion fixed paraffin-embedded sections of human spleen
Sample: Immersion fixed paraffin-embedded sections of human spleen
Western Blot
2 µg/mL
Sample: Human peripheral blood mononuclear cells (PBMC) and human peripheral blood granulocytes
Sample: Human peripheral blood mononuclear cells (PBMC) and human peripheral blood granulocytes
Formulation, Preparation, and Storage
Purification
Protein A or G purified from cell culture supernatant
Reconstitution
Reconstitute at 0.5 mg/mL in sterile PBS. For liquid material, refer to CoA for concentration.
Formulation
Lyophilized from a 0.2 μm filtered solution in PBS with Trehalose. See Certificate of Analysis for details.
*Small pack size (-SP) is supplied either lyophilized or as a 0.2 µm filtered solution in PBS.
*Small pack size (-SP) is supplied either lyophilized or as a 0.2 µm filtered solution in PBS.
Shipping
Lyophilized product is shipped at ambient temperature. Liquid small pack size (-SP) is shipped with polar packs. Upon receipt, store immediately at the temperature recommended below.
Stability & Storage
Use a manual defrost freezer and avoid repeated freeze-thaw cycles.
- 12 months from date of receipt, -20 to -70 °C as supplied.
- 1 month, 2 to 8 °C under sterile conditions after reconstitution.
- 6 months, -20 to -70 °C under sterile conditions after reconstitution.
Background: CEACAM-8/CD66b
CEACAM-8 (Carcinoembryonic Antigen-related Cell Adhesion Molecule 8), also known as CD66b, CD67 and NCA-95, is a 90 kDa member of the CEACAM subfamily of the CEA family of proteins. It is expressed by neutrophils and eosinophils, and serves as a binding partner for CEACAM-6 and Galectin-3. Mature human
CEACAM-8 is a 287 amino acid GPI-linked glycoprotein. It contains one V-type and two C2-type Ig-like domains. No definitive rodent CEACAM-8 has been reported.
Long Name
Carcinoembryonic Antigen-related Cell Adhesion Molecule 8
Alternate Names
CD66b, CD67, CEACAM8, CGM6, NCA-95
Gene Symbol
CEACAM8
UniProt
Additional CEACAM-8/CD66b Products
Product Documents for Human CEACAM-8/CD66b Antibody
Product Specific Notices for Human CEACAM-8/CD66b Antibody
For research use only
Loading...
Loading...
Loading...
Loading...
Loading...
Loading...